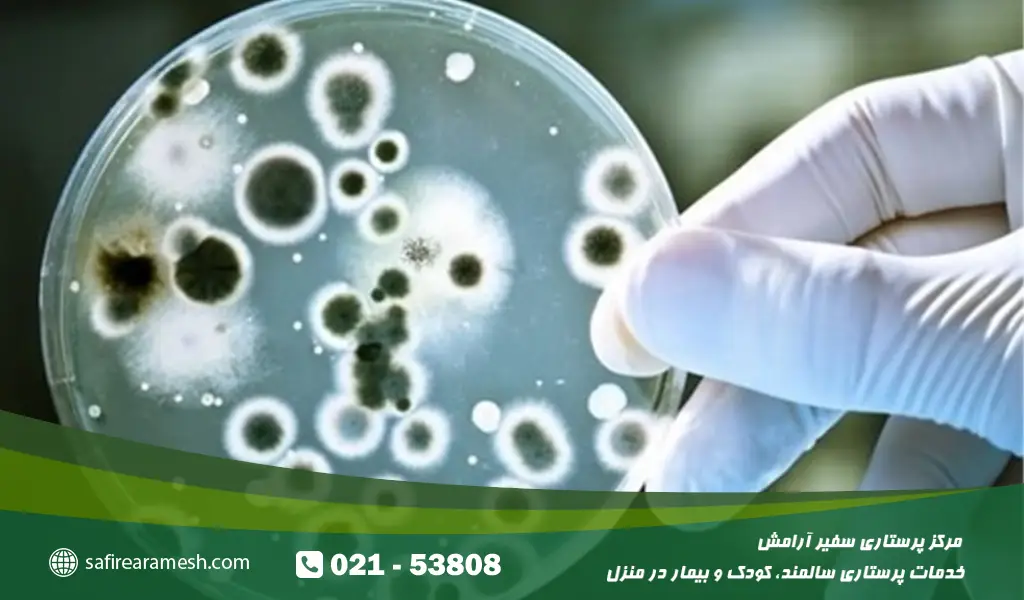
تشخیص علائم عفونت ادراری در کودکان

عفونت ادراری (UTI) یکی از شایعترین بیماریهای باکتریایی در کودکان است که میتواند بخشهای مختلف دستگاه ادراری، از جمله مثانه، حالب، یا کلیهها را درگیر کند. این بیماری بهویژه در نوزادان و کودکان زیر 7 سال رایج است و طبق گزارش کلینیک کلیولند، حدود 8% کودکان در این سنین حداقل یکبار به آن مبتلا میشوند.
اگر این بیماری بهموقع تشخیص داده نشود یا درمان نشود، میتواند عوارض جدی مانند آسیب دائمی به کلیهها، نارسایی کلیوی، یا حتی فشار خون بالا در بزرگسالی ایجاد کند. این مقاله به سوال رایج والدین پاسخ میدهد: عفونت ادراری چیست، چگونه تشخیص داده میشود، و چه روشهای درمانی و پیشگیری وجود دارد؟ ما بهطور جامع به علل، علائم، روشهای تشخیصی، درمانهای دارویی و خانگی، و راهکارهای پیشگیری میپردازیم تا والدین و پرستار کودک بتوانند با آگاهی کامل از سلامت فرزندشان محافظت کنند.
عفونت ادراری در کودکان چیست؟
عفونت ادراری زمانی رخ میدهد که باکتریها، اغلب Escherichia coli (E. coli) از روده، از طریق مجرای ادرار وارد دستگاه ادراری شوند و در مثانه یا کلیهها تکثیر پیدا کنند. این بیماری در کودکان به دلیل سیستم ایمنی در حال رشد و ویژگیهای آناتومیکی مانند مجرای ادرار کوتاهتر در دختران یا مشکلات مادرزادی در پسران شایعتر است. عفونت ادراری میتواند به دو نوع اصلی تقسیم شود:
-
سیستیت: عفونت در مثانه یا مجرای ادرار تحتانی که معمولاً با علائم خفیفتر مانند سوزش ادرار همراه است.
-
پیلونفریت: عفونت در کلیهها یا حالب که خطرناکتر است و میتواند به تب شدید، درد پهلو، و آسیب کلیوی منجر شود.
تشخیص این بیماری در کودکان خردسال چالشبرانگیز است، زیرا آنها نمیتوانند علائم را بهخوبی بیان کنند. به همین دلیل، والدین باید به نشانههای غیراختصاصی مانند تب در کودکان با منشا بدون دلیل، بیقراری، یا تغییر در الگوی ادرار توجه ویژهای داشته باشند. عفونتهای مکرر (بیش از دو بار در سال) ممکن است نشانهای از مشکلات ساختاری مانند رفلاکس ادراری (بازگشت ادرار از مثانه به کلیه) باشند که نیاز به بررسی دقیقتر دارد.
علل و عوامل خطر عفونت ادراری در کودکان
عفونت ادراری معمولاً به دلیل ورود باکتری از روده به مجرای ادرار ایجاد میشود، اما عوامل متعددی میتوانند خطر ابتلا را افزایش دهند:
- عدم رعایت بهداشت: تمیز نکردن صحیح ناحیه تناسلی، بهویژه در کودکان پوشکپوش، باعث انتقال باکتری از مقعد به مجرای ادرار میشود. در دختران، تمیز کردن از عقب به جلو خطر را افزایش میدهد.
- یبوست مزمن: تجمع مدفوع در روده باعث تکثیر باکتریها و انتقال آنها به مجرای ادرار میشود. حدود 30% کودکان با یبوست مزمن به عفونت ادراری مبتلا میشوند.
- رفلاکس ادراری (VUR): بازگشت ادرار از مثانه به کلیهها، که در 30-50% کودکان با عفونتهای مکرر دیده میشود، خطر آسیب کلیوی را افزایش میدهد.
- ختنه نشدن در پسران: مطالعات نشان میدهد پسران ختنهنشده تا 10 برابر بیشتر در معرض عفونت ادراری هستند، بهویژه در سال اول زندگی.
- مشکلات مادرزادی: مانند تنگی مجرای ادرار، سنگ کلیه، یا انسداد حالب.
- عوامل دیگر: ضعف سیستم ایمنی (به دلیل بیماریهایی مانند دیابت)، استفاده طولانی از پوشک کثیف، یا نگه داشتن ادرار برای مدت طولانی.
دختران به دلیل مجرای ادرار کوتاهتر (2-3 سانتیمتر در مقایسه با 10-12 سانتیمتر در پسران) بیشتر مستعد هستند، در حالی که پسران ممکن است به دلیل مشکلات ساختاری مانند تنگی پیشابراه در معرض خطر باشند.
درسایت my.clevelandclini میخوانیم:
اگر فرزند شما موارد زیر را داشته باشد، ممکن است در معرض خطر بیشتری برای عفونت ادراری باشد:
- رفلاکس مثانه به حالب داشته باشد، وضعیتی که ادرار از مثانه به سمت کلیهها برمیگردد.
- یبوست داشته باشد، که میتواند جریان طبیعی ادرار را مسدود کند.
- تفاوتهایی در دستگاه ادراری خود داشته باشد (مانند دریچههای خلفی مجرای ادرار یا حالبهای بزرگ).
- هنگام نیاز به دستشویی، ادرار خود را نگه دارد.
علائم عفونت ادراری در کودکان
علائم عفونت ادراری بسته به سن، جنسیت، و شدت بیماری متفاوت است. در ادامه، علائم را به تفکیک گروههای سنی و جنسیتی بررسی میکنیم.
علائم در نوزادان (زیر 12 ماه)
نوزادان به دلیل ناتوانی در بیان علائم، نشانههای غیراختصاصی نشان میدهند که نیاز به توجه دقیق والدین دارد:
- تب بدون دلیل (بالاتر از 38 درجه سانتیگراد) که ممکن است تنها علامت باشد.
- کاهش وزن یا عدم افزایش وزن مناسب.
- ادرار بدبو، کدر، یا حاوی خون.
- بیقراری، گریه مداوم، یا تحریکپذیری.
- استفراغ، اسهال، یا زردی پوست.
- کاهش اشتها یا مشکل در شیر خوردن.
علائم در کودکان دختر
دختران به دلیل ساختار آناتومیکی مجرای ادرار کوتاهتر، علائم موضعی بیشتری نشان میدهند:
- سوزش ادرار یا درد هنگام ادرار که ممکن است کودک را از دستشویی رفتن بترساند.
- تکرر ادرار، حتی اگر حجم ادرار کم باشد.
- بیاختیاری ادرار (خیس کردن لباس یا رختخواب).
- درد در ناحیه پایین شکم یا اطراف واژن.
- ادرار بدبو، کدر، یا حاوی خون.
- تب خفیف، خستگی، یا کاهش انرژی.
علائم در کودکان پسر
پسران ممکن است علائم کلیتری داشته باشند که تشخیص را دشوارتر میکند:
- درد یا تورم در ناحیه آلت تناسلی.
- جریان ضعیف ادرار یا مشکل در شروع ادرار.
- درد در پشت، پهلو، یا زیر دندهها (نشانه عفونت کلیه).
- تب، لرز، یا حالت تهوع.
- ادرار کدر، بدبو، یا خونی.
- کاهش اشتها یا بیحالی.
اگر علائم با تب بالا، لرز شدید، یا درد شدید پهلو همراه باشد، ممکن است عفونت به کلیهها رسیده باشد که نیاز به درمان فوری دارد. در موارد مشکوک، والدین باید مخصوصا ضمن توجه به نکات کلیدی مراقبت از نوزاد پسر سریعاً به پزشک مراجعه کنند.
تشخیص عفونت ادراری در کودکان
تشخیص دقیق عفونت ادراری نیازمند معاینه پزشکی و آزمایشهای تخصصی است. مراحل تشخیص شامل موارد زیر است:
-
معاینه فیزیکی: پزشک علائم مانند تب، درد شکم، یا تورم ناحیه تناسلی را بررسی میکند.
-
آزمایش ادرار:
-
آنالیز ادرار (U/A): بررسی فاکتورهایی مانند نیتریت، گلبولهای سفید، پروتئین، و قند. نیتریت مثبت معمولاً نشانه عفونت باکتریایی است.
-
کشت ادرار (U/C): شناسایی نوع باکتری و حساسیت آن به آنتیبیوتیکها، که 2-3 روز طول میکشد.
-
آزمایش ادرار 24 ساعته: برای بررسی دفع پروتئین و شدت آسیب کلیوی.
-
-
تصویربرداری: در موارد شدید یا عفونتهای مکرر، پزشک ممکن است سونوگرافی کلیه و مثانه یا VCUG (سیستوگرافی مثانه) را برای بررسی رفلاکس ادراری یا انسداد تجویز کند.
در نوزادان، نمونه ادرار با کیسه استریل یا کاتتر جمعآوری میشود تا از آلودگی جلوگیری شود. در کودکان بزرگتر، نمونه ادرار تمیز (midstream) مناسب است. دقت در جمعآوری نمونه برای جلوگیری از نتایج کاذب ضروری است.
جدول آزمایشهای تشخیص عفونت ادراری
| آزمایش | هدف | زمان نتیجهگیری | کاربرد |
|---|---|---|---|
| آنالیز ادرار (U/A) | بررسی نیتریت، گلبول سفید، پروتئین، و قند | چند ساعت | تشخیص اولیه عفونت |
| کشت ادرار (U/C) | شناسایی نوع باکتری و حساسیت به آنتیبیوتیک | 2-3 روز | انتخاب بهترین آنتیبیوتیک |
| ادرار 24 ساعته | بررسی دفع پروتئین و آسیب کلیوی | 1-2 روز | ارزیابی شدت آسیب کلیوی |
| سونوگرافی کلیه و مثانه | بررسی ساختار دستگاه ادراری و رفلاکس | چند ساعت | تشخیص مشکلات مادرزادی یا رفلاکس ادراری |
درمان عفونت ادراری در کودکان
درمان عفونت ادراری در کودکان به شدت بیماری، سن کودک، و نتایج آزمایش بستگی دارد. هدف اصلی درمان، حذف باکتریها و جلوگیری از عوارض است.
درمان دارویی با آنتیبیوتیک
آنتیبیوتیکها ستون اصلی درمان هستند و بر اساس نتیجه کشت ادرار تجویز میشوند. رایجترین آنتیبیوتیکها عبارتند از:
- نیتروفورانتوئین: بهترین گزینه برای عفونتهای ساده مثانه، بهصورت شربت یا قرص، با عوارض کم.
- سفیکسیم: با دوز 8 میلیگرم به ازای هر کیلوگرم وزن در روز (در دو دوز تقسیمشده)، برای عفونتهای مقاوم.
- آموکسیسیلین: برای موارد خفیف یا بهعنوان پیشگیری.
- سفالکسین یا سفپروزیل: مناسب برای عفونتهای کلیه (پیلونفریت).
- سولفامتوکسازول: برای پیشگیری در موارد عفونت مکرر.
دوره درمان معمولاً 3-7 روز برای سیستیت و 10-14 روز برای پیلونفریت است. در موارد شدید، مانند عفونت کلیه در نوزادان، بستری در بیمارستان و تزریق آنتیبیوتیک وریدی (مانند سفتریاکسون) لازم است. والدین باید دوره درمان را کامل کنند، حتی اگر علائم بهبود یافت، تا از عود عفونت جلوگیری شود.
درمانهای خانگی و مکمل
درمانهای خانگی میتوانند علائم را تسکین دهند، اما جایگزین آنتیبیوتیک نیستند:
- مصرف مایعات زیاد: نوشیدن آب، آبمیوه طبیعی (مانند کرنبری که از چسبندگی باکتری به دیواره مثانه جلوگیری میکند)، یا چایهای گیاهی ملایم.
- حمام آب گرم: برای کاهش اسپاسم مثانه و تسکین درد.
- رژیم غذایی غنی از ویتامین C: مانند مرکبات، برای اسیدی کردن ادرار و کاهش رشد باکتری.
- اجتناب از محرکها: مانند نوشابه، غذاهای تند، یا کافئین که مثانه را تحریک میکنند.
- دمنوشهای گیاهی: مانند جوشانده جعفری یا بابونه، اما فقط با مشورت پزشک.
برای تسکین درد یا تب، میتوان از پاراستامول (با دوز مناسب سن کودک) استفاده کرد. اگر علائم پس از 48 ساعت بهبود نیافت، باید به پزشک مراجعه شود.
چه زمانی به پزشک مراجعه کنیم؟
مراجعه فوری به پزشک در موارد زیر ضروری است:
- تب بالای 38 درجه سانتیگراد، بهویژه بدون دلیل مشخص.
- درد شدید شکم، پهلو، یا پشت.
- استفراغ مکرر، خوابآلودگی، یا بیحالی شدید.
- نوزاد زیر 3 ماه با هرگونه علامت مشکوک.
- عدم بهبود علائم پس از 48 ساعت مصرف آنتیبیوتیک.
در موارد خفیفتر، مشاوره آنلاین با دکتر عفونی یا اطفال میتواند راهگشا باشد. تأخیر در درمان ممکن است خطر آسیب کلیوی را افزایش دهد.
روشهای پیشگیری از عفونت ادراری در کودکان
پیشگیری از عفونت ادراری نهتنها از بروز بیماری جلوگیری میکند، بلکه هزینههای درمان و عوارض را کاهش میدهد. راهکارهای زیر توصیه میشود:
-
رعایت بهداشت ناحیه تناسلی: تمیز کردن از جلو به عقب، بهویژه در دختران، و تعویض منظم پوشک.
-
درمان یبوست: با رژیم غذایی پر فیبر (مانند میوهها و سبزیجات) یا ملینهای تجویز شده توسط پزشک.
-
تشویق به نوشیدن مایعات: حداقل 6-8 لیوان آب در روز برای کودکان بزرگتر.
-
آموزش توالت رفتن: تشویق کودکان به تخلیه منظم مثانه و اجتناب از نگه داشتن ادرار.
-
ختنه در پسران: کاهش خطر عفونت تا 90% در سال اول زندگی.
-
بررسی مشکلات مادرزادی: در صورت عفونتهای مکرر، معاینه برای رفلاکس ادراری یا انسداد ضروری است.
در کودکانی که عفونتهای مکرر دارند، پزشک ممکن است آنتیبیوتیک با دوز پایین (مانند نیتروفورانتوئین) برای پیشگیری طولانیمدت تجویز کند.
عوارض احتمالی عفونت ادراری درماننشده
اگر عفونت ادراری بهموقع درمان نشود، میتواند عوارض جدی ایجاد کند:
-
آسیب کلیوی: بهویژه در پیلونفریت، که میتواند به زخم دائمی کلیه منجر شود.
-
نارسایی کلیوی: در موارد شدید یا عفونتهای مکرر.
-
فشار خون بالا: به دلیل آسیب به عروق کلیوی.
-
سپسیس: در موارد نادر، گسترش عفونت به خون که یک اورژانس پزشکی است.
تشخیص زودهنگام و درمان مناسب میتواند این خطرات را به حداقل برساند.
سخن پایانی
عفونت ادراری در کودکان یک بیماری شایع اما قابلکنترل است که با تشخیص زودهنگام و درمان مناسب میتوان از عوارض آن جلوگیری کرد. والدین نقش کلیدی در شناسایی علائم، رعایت بهداشت، و پیگیری درمان دارند. اگر نگران سلامت فرزندتان هستید، با پزشک اطفال یا عفونی مشورت کنید و از راهکارهای پیشگیری مانند نوشیدن مایعات و تعویض منظم پوشک بهره ببرید. نظرات و تجربیات خود را با ما در میان بگذارید تا به دیگر والدین کمک کنید.
سوالات متداول
علائم عفونت ادراری در کودکان دختر چیست؟
سوزش یا درد هنگام ادرار، تکرر ادرار، بیاختیاری، درد پایین شکم، و ادرار بدبو یا خونی.
علائم عفونت ادراری در کودکان پسر چیست؟
درد ناحیه تناسلی، جریان ضعیف ادرار، تب، درد پهلو، و ادرار کدر.
بهترین آنتیبیوتیک برای عفونت ادراری کودکان چیست؟
نیتروفورانتوئین برای عفونتهای ساده و سفیکسیم برای موارد مقاوم، با تجویز پزشک.
درمان خانگی عفونت ادراری کودکان چیست؟
نوشیدن مایعات زیاد، حمام آب گرم، و مصرف غذاهای غنی از ویتامین C، اما همیشه مکمل درمان دارویی است.
سفیکسیم برای عفونت ادراری کودکان چقدر مؤثر است؟
بسیار مؤثر برای باکتریهای مقاوم، اما دوز و مدت مصرف باید توسط پزشک تعیین شود.
عفونت ادراری مکرر نشانه چیست؟
ممکن است به رفلاکس ادراری، مشکلات مادرزادی، یا عدم رعایت بهداشت مرتبط باشد.